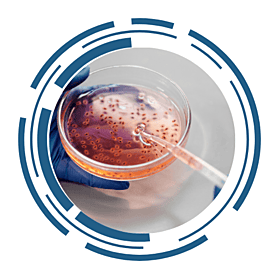
A gloved hand holding a petri dish containing a liquid culture with small specimens, while using a pipette to transfer liquid. The image is framed by a circular, futuristic design.

AIS LIMS Modules
AIS LIMS is a generic Laboratory Information Management System that provides the tools required to help operate and efficiently manage your laboratory processes. The AIS LIMS system can be configured to meet virtually any organisation’s specific needs and requirements, allowing you to save time and costs by automating tasks, integrating equipment and systems and streamlining processes.
Core Modules - Included with all LIMS Systems
AIS LIMS allows samples to be registered quickly and efficiently into the system. All samples logged into your Laboratory Information Management System will be given unique sample numbers. All actions performed against a sample are recorded to ensure traceability and regulatory compliance. Samples can be registered individually or in groups and can be registered from files created from sampling programs, stability profiles, or other systems such as AIS labPortal.
The screens used for registration are highly configurable, allowing you to record the information that is relevant to your operation and in familiar terminology. Labels displaying sample numbers as barcodes, plus relevant and useful sample information, can be designed and produced, as can complete lists of registered samples and required tests. Sample receipts/confirmations containing registered sample details and pricing can be emailed directly to clients for confirmation before commencing analysis.
AIS LIMS offers several ways in which work can be scheduled and automated. Worksheets can be generated to be used as result entry forms and worklists can be generated for daily laboratory workloads, instrument loading etc. These are simple to use and allow the inexperienced user to enter data into the system quickly and accurately, limiting the opportunity for errors.
AIS LIMS allows results to be entered in a variety of formats, supporting various required inputs. It allows results to be entered manually at the keyboard or automatically from instrument files and for simpler interfaces (e.g. balances) through a keyboard capture system. Data captured directly from laboratory instruments gives benefits in data accuracy and in the speed of data entry, which improves the performance and efficiency of the lab. User training records, instrument records and analytical quality control (AQC) targets are utilised by the software for results entered or generated in order to ensure validity, accuracy and precision.
AIS LIMS supports the use of user-defined calculations in its worksheets and has the ability to automatically extract results from the database and process calculations internally. This automation removes errors made during manual calculation processing and eliminates the need for costly retesting. Any changes to the input values automatically trigger the recalculation of derived values.
AIS LIMS will also check all entered results against predefined limits, alerting the user to a variety of limit breaches and allowing further work to be scheduled automatically for the sample if required.
The sample approval process allows designated users with permissions to allocate “validated”, "approved", "failed", or “withdrawn” status to a sample or group of samples. During the approval stage, (which may also be automated) the user can examine all data associated with the sample. This includes associated documents, audit trail, quality (AQC) data and historical results so that these can be evaluated before approving samples. General, specific, or statistical limits which are applicable can be displayed and limit infringements highlighted and brought to the attention of the user before approving results.
AIS LIMS includes a proprietary report designer which allows trained users to create any number of report templates. AIS LIMS also supports third-party reporting tools such as Microsoft Excel. This flexibility in 'output source' ensures compatibility and customer satisfaction.
AIS LIMS reporting modules allow you to deliver results to your customers in a number of different formats. We offer several different report styles for both hard copy and electronic output of both individual and multi-sample reports which the user is able to select and customise
Optional Additional Modules
Analytical Quality Control (AQC) is a framework for monitoring the accuracy and precision of analytical measurements. The main purpose of AQC is to:
- Provide confidence in analytical measurements
- Demonstrate compliance with performance targets
- Obtain timely warnings of deteriorating trends
- Validate new analytical methods or instrumentation
- Meet requirements of accreditation schemes (e.g. UKAS, MCERTS, INAB)
AIS LIMS AQC software is an optional module which can be purchased to provide a basis for interactively scheduling, recording and checking analytical results against known quality standards. This ensures the reliability of results and helps to improve performance and maintain accuracy.
The AQC module is capable of measuring multiple standards and known reference materials as well as duplicate sample analyses and recovery in spiked samples. AQC warnings and actions are audited and are displayed during result entry and approval processes. AQC results can be reported as a statistical summary and control charts can be generated to allow trends to be monitored. Automated processes can be configured to generate a series of AQC charts for selected determinations. AQC breaches are automatically logged and stored as part of the software’s audit trail which is essential for traceability.
The Auto Approval module streamlines your workflow by automatically reviewing results against a configurable set of rules. Each result is evaluated based on predefined criteria, ensuring consistency and accuracy without manual intervention. When all conditions are met, results are automatically approved, allowing the associated job to progress without delay.
Because this process is fully automated, it can deliver significant time savings for the laboratory, reducing manual workload and enabling staff to focus on higher-value tasks.
For cases that do not meet the required standards, the module provides a dedicated review area where users can easily identify failed results. From here, users can investigate issues and apply manual approval when appropriate, ensuring full control and flexibility over the approval process.
The Auto Reporting module automatically generates reports for all approved jobs and distributes them directly to clients via email. By removing the need for manual report creation and sending, it ensures timely, consistent reporting with minimal effort.
As a fully automated process, it delivers significant time savings for the laboratory, reducing administrative workload and allowing staff to focus on more critical tasks.
The Enhanced Auto Reporting module builds on standard automation by not only generating and sending reports for approved jobs, but also enabling the creation of supplementary reports alongside the main report. This provides greater flexibility to meet specific client or regulatory requirements without additional manual steps.
Like the standard module, this fully automated process drives substantial time savings for the laboratory, while enhancing reporting capabilities and maintaining consistent, efficient delivery to clients.
The Breaches module automatically notifies clients when results exceed defined thresholds. Based on configurable settings, notifications can be triggered as soon as a result is entered or upon approval, ensuring timely and accurate communication. Each alert is delivered via customised emails containing the relevant breached results, tailored to client requirements.
All notifications are handled seamlessly in the background, allowing the process to run without interrupting users’ workflow. This automation not only ensures rapid response to critical results but also delivers valuable time savings for the laboratory by reducing the need for manual monitoring and communication.
The Control Centre serves as a centralised hub for managing, monitoring, and controlling all lab activities. It provides a real-time overview of key operations, allowing users to make informed decisions, streamline workflows, and maintain compliance.
The Cubes module is purpose-built for concrete cube testing, providing a streamlined workflow tailored to industry requirements. It includes a dedicated registration process, intuitive result entry screens, and cube-specific reporting to ensure accurate and efficient data handling throughout the testing lifecycle.
Designed to support BS EN cube crushing strength testing, the module helps laboratories maintain compliance with relevant standards while improving consistency and reducing manual effort. By aligning processes specifically to concrete cube testing, it enhances efficiency, accuracy, and overall productivity.
The Customised Excel Worksheet module enables laboratories to generate tailored Excel worksheets directly from the LIMS using predefined templates. These can include macro-enabled spreadsheets, allowing labs to incorporate their own calculations, formatting, and workflows.
Once completed, the worksheets are automatically imported back into the LIMS, ensuring a seamless flow of data without manual re-entry. This approach allows laboratories to continue using their own bespoke Excel-based processes while maintaining full integration, improving efficiency and reducing the risk of transcription errors.
The Data Reporting module enables laboratories to generate a range of standardised regulatory data reports as supplements to report certificates, including AGS, AGS4, HWOL, ESDAT, EQUIS and XML formats. Designed to meet specific regulatory requirements, it ensures accurate and consistent reporting and works seamlessly with any regulatory file checker.
To further enhance efficiency, the module can be linked with the Enhanced Auto Reporting module to automate report generation and distribution, saving time and reducing administrative workload.
The Financial module provides comprehensive control over laboratory pricing and billing, with dedicated functionality for both quotations and invoicing.
The Quotes component allows laboratories to create detailed quotations for one-off work or define contract-specific rates for client pricing over a set period of time, ensuring accuracy and consistency. Quotes can also be generated and emailed directly to clients.
The Invoicing component enables the efficient generation of invoices once jobs become eligible for billing within the LIMS. This streamlines the billing process, ensures timely and accurate financial management, and allows invoices to be emailed directly to clients.
By bringing quotes and invoicing together within the LIMS, the module reduces administrative effort, improves consistency, and provides full visibility over financial operations. AIS LIMS can also be configured to generate files for interfacing with external financial packages.
The Microbiology module is designed to support efficient and accurate microbiological testing workflows. It enables the generation of plate barcode labels, which are used throughout the result entry process to ensure efficient and accurate data capture. Colony counts are recorded, and ISO serial dilution calculations are automatically applied to determine the final result.
The module also includes incubation tracking and a media log, providing complete oversight of sample progression and laboratory resources.
The Result Interfaces module automates the import of instrument data into the LIMS, supporting a wide range of file formats, including Excel, CSV, Text, and XML. By automatically translating and importing results, it eliminates manual transcription, reducing errors and saving valuable time for laboratory staff.
The module works seamlessly with the LIMS analytical limit checks and AQC module, while also providing its own blank correction process to ensure data accuracy. Additionally, it supports the import of Microbiology plate reader files, making it a versatile solution for a variety of laboratory workflows.
The Subcontractor module enables laboratories to efficiently manage and schedule work for subcontracted laboratories. It provides clear visibility and control over outsourced testing, ensuring that samples are assigned, tracked, and dispatched effectively. The module also allows for reports and chain of custody documentation to be produced for all subcontracted samples and analyses.
By centralising subcontractor workflows within the LIMS, the module helps reduce manual coordination, improve turnaround times, and maintain full traceability of externally processed work.